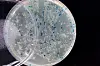

Antibiotic-resistant bacteria are everywhere
Nasty superbugs – bacteria resistant to nearly every antibiotic – are not just found in chicken fillets. They can be anywhere, from your kitchen counter to the local creek. There’s no way to know if you're carrying them around inside you, either. Not until you're in trouble.
Denne artikkelen er over ti år gammel og kan inneholde utdatert informasjon.
Norwegians lost their taste for chicken in September 2014, when newspaper headlines warned consumers that antibiotic-resistant bacteria had been found in one-third of chicken fillets sold in Norwegian supermarkets.
Experts revealed that they themselves avoided touching chicken meat with their fingers for fear of ingesting the resistant bacteria.
The demand for chicken meat nationwide plummeted.
The only problem is that chicken fillets may be the least of our problems when it comes to antibiotic-resistant superbugs.
Even low concentrations a problem
Recent research suggests that resistant bacteria can be found in most environments where there are humans and livestock, says Professor Yngvild Wasteson, of the Department of Food Safety and Infection Biology at the Norwegian University of Life Sciences (NMBU).
These bacteria have either evolved in the bodies of animals or people who have used antibiotics, or occur because antibiotics find their way into water or soil.
Even low concentrations of antibiotic contamination can cause bacteria to develop resistance. And the more that antibiotics are used in a particular place, the higher the risk is of encountering resistant bacteria in that area.
Wasteson says that Norway has done a relatively good job of limiting antibiotic use, so that resistant bacteria are less of a problem here than in many other countries. There’s a much higher risk of encountering problem bacteria in places like southern and eastern Europe, and in Southeast Asia, where antibiotic use is widespread.
May take years to cause problems
India is a superbug hot spot. Spending just 48 hours in New Delhi is long enough to bring home the worst types of resistant bacteria in your gut, says Trine L'Abee-Lund, an associate professor at NMBU’s Veterinary College.
The problem with antibiotic-resistant bacteria is that they may not make you sick right away.
It’s only later, sometimes years later, if your immune system is weakened, that resistant bacteria may cause a problem. Your doctor may treat you with antibiotics, but none of them work.
Swapping genes
Bacteria also have another unfortunate trait that makes resistance a problem: They swap genes.
Bacteria can simply exchange snippets of DNA with each other. This spreads antibiotic resistance from bacterium to bacterium, as well as between different species of bacteria.
Wasteson described one experiment conducted by NMBU researchers in 1994, in which they contaminated a hand towel with resistant bacteria from animals and common bacteria from humans, and let the towel sit at room temperature.
Within minutes the genes for antibiotic resistance had been added to the human bacteria.
This means the bacteria that travel from India in your gut can share their antibiotic resistance with other bacteria in your body or environment. The worst case is when dangerous, pathogenic bacteria acquire these new features.
Can persist for years
Scientists know relatively little about resistant bacteria – from their lifespan in your body to the numbers and species in the environment.
Researchers have found resistant genes virtually everywhere, even areas that are not affected by human use of antibiotics, because bacteria and fungi naturally evolve antibiotic properties.
L'Abee-Lund says that recent studies of sediments under fish farms found bacteria with antibiotic resistance, even years after the industry stopped using fish antibiotics in feed.
All antibiotic use matters
It may seem futile to prevent unnecessary use of antibiotics for ear infections here in Norway, when other parts of the world are liberally dispensing drugs to people and animals.
But Wasteson and L'Abee-Lund say all antibiotic use matters.
“Any use of antibiotics can cause resistant bacteria to develop,” they say. “It is important to limit antibiotic use to cases where you really need it.”
——————————-
Read the Norwegian version of this article on forskning.no